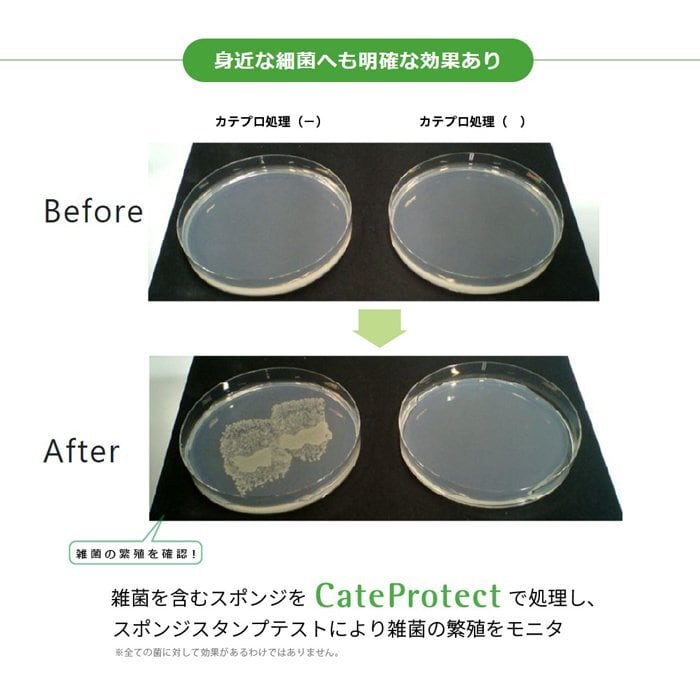

・翌月にまとめてお支払い可能
・手数料無料(口座振替の場合)
・アプリでご利用金額を確認できて安心

¥1,430 税込
なら 手数料無料の 翌月払いでOK
別途送料がかかります。送料を確認する
お茶由来の安全な抗ウイルス成分「カテプロテクト」でウイルスを不活化させます!
マスクスプレーをすると、マスク全体をコーティングしてくれるので、マスクの穴を通過しようとするウイルスをキャッチして除去!
爽やかな香りで消臭効果も抜群です!
■成分:カテプロテクト(カテキン脂肪酸エステル)、DPC、精製水、クエン酸塩、グリチルリチン酸、防腐剤、香料
■内容量:60ml
■使用法:マスクの外側に2〜3プッシュし、表面をコーティング後、乾かしてから装着します。効果は1〜2時間。
■保管方法:0℃以下の場所や、高温多湿や直射日光は避けて保管してください。
【使用上の注意】
●本品は食品ではありません。●万一飲み込んだ場合は医師に相談してください。●目に入った場合は擦らず水で洗い流してください。●皮膚の弱い方が中身に直接触れるとかぶれる恐れがありますので石鹸等でよく洗い流してください。●万一不快な症状見られる場合は使用を中止してください。●人や動物に向かって噴霧しないでください。●製品特質上稀に成分由来の沈殿物や変色、濁りが見られる場合がありますが使用には問題ありません。
送料・配送方法について
お支払い方法について